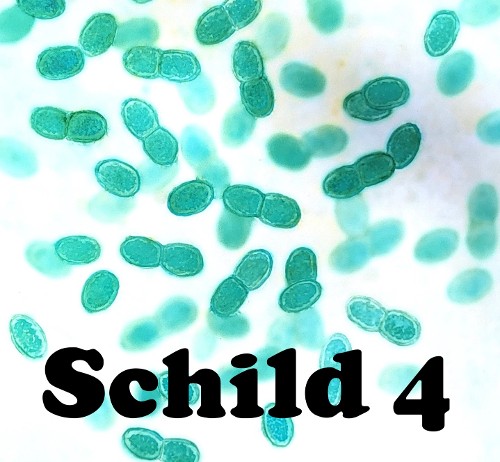
ERSTE CYANOBAKTERIEN (vor 3.500 Mio. Jahren)

ZUM MITLESEN:
Sie fragen sich vielleicht, ob Cyanobakterien wirklich ihr ganz eigenes Schild verdient haben? Ich kann Ihnen sagen: Ja, diese Ehre haben sie definitiv verdient! Ihre Rolle kann gar nicht hoch genug eingeschätzt werden, denn Cyanobakterien werden die Erde von Grund auf verändern, und das tun sie bis heute.
1. Photosynthese
Cyanobakterien haben nämlich eine ganz spezielle Fähigkeit: Sie können Photosynthese! Das bedeutet, dass sie zur Energiegewinnung das Licht der Sonne nutzen können. Außer Licht benötigen sie nur noch Kohlendioxid und Wasser, was beides ja ebenfalls unbegrenzt zur Verfügung steht. Und aus diesen drei Zutaten produzieren sie Glucose, also Zucker. Photosynthese ist wirklich eine ganz fantastische Fähigkeit, die bis heute nur diese Art von Bakterien geschafft hat.
2. Sauerstoff
Aber jetzt fragen sie sich, was an Photosynthese so Besonderes ist, dass die die ganze Erde verändert haben soll? Die Antwort darauf lautet: Sauerstoff! Der entsteht nämlich bei dem chemischen Prozess der Photosynthese als eine Art Abfallprodukt. Und ungebundener Sauerstoff ist auf der Erde etwas komplett Neues.
Das Spezielle an ihm ist, dass es sich um ein extrem reaktionsfreudiges Element handelt. Sauerstoff reagiert mit allen möglichen Stoffen, denen er begegnet. So auch mit Eisen-Molekülen, die zu dieser Zeit im Ozean massenhaft vorhanden sind. Und weil Rost entsteht, wenn Sauerstoff und Eisen miteinander reagieren, setzt sich nun sehr viel Rost auf dem Meeresgrund ab. Das ist der Grund, weshalb sich heute in den Gesteinsschichten aus dieser Zeit breite rote Rostbänder finden.
3. Erstes Massenaussterben
Und was bedeutet der reaktionsfreudige Sauerstoff für das Leben auf der Erde? Wirklich nichts Gutes. Denn die Einzeller haben noch nicht gelernt, mit diesem Element umzugehen. Der Sauerstoff greift ihre Zellen an und zerstört sie. Das führt zum ersten Massenaussterben der Weltgeschichte: der „Großen Sauerstoffkatastrophe“!
Sogar die Cyanobakterien selbst haben schwer mit dem Sauerstoff zu kämpfen, den sie produzieren. Das kann man gut an den verschiedenen Schichten der Rostbänder ablesen. Man sieht dort, dass ihre Anzahl über die Jahrmillionen stark schwankt. Ja, es dauert eben, bis sich Mutationen durchsetzen, die mit dem Sauerstoff zurechtkommen.
Und dieses Massenaussterben ist noch nicht mal alles, was die Photosynthese auf der Erde so anrichten wird. Gehen Sie zum nächsten Schild und erfahren sie, wie die Photosynthese die Erde noch weiter grundlegend verändert.